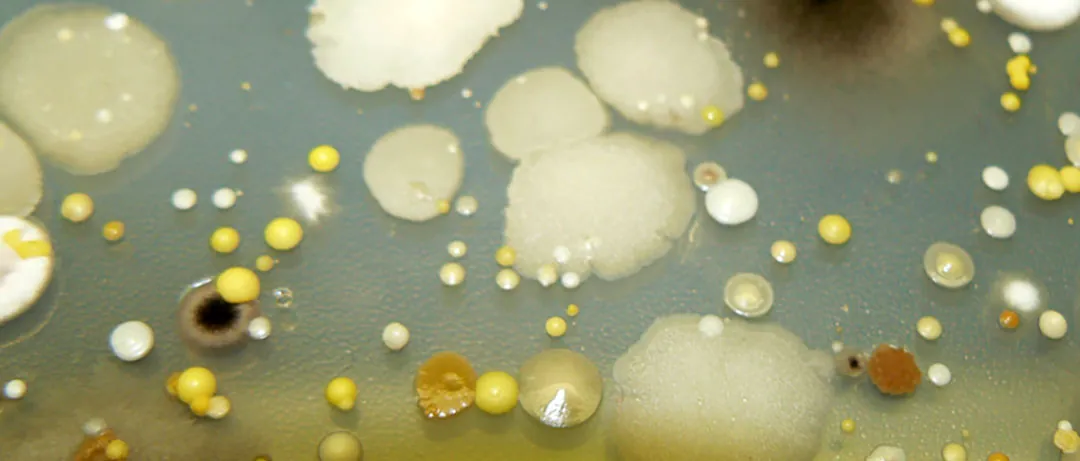
Cultivo de microorganismos en placa petri

El sector agrícola se encuentra en una constante evolución, impulsada por la necesidad de conjugar productividad y sostenibilidad. En este escenario, el uso de microorganismos como insumos agrícolas ha dejado de ser una alternativa para convertirse en una herramienta fundamental en la gestión de los cultivos.
Lejos de ser una novedad, su aplicación se basa en la comprensión profunda de los procesos biológicos que rigen la salud del suelo y el desarrollo de las plantas, alineándose con las directrices del Pacto Verde Europeo y la estrategia De la Granja a la Mesa. Además, hay que destacar que a nivel de legislación europea, estos se encuentran incluidos en el Real Decreto de fertilizante, dentro del apartado de los bioestimulantes de plantas, y en concreto, en el apartado de bioestimulantes microbianos.
Si bien el uso de microorganismos es una práctica ancestral en procesos como la elaboración de pan, vino o yogur, etc. su aplicación controlada en la agricultura representa una de las bases de la biotecnología moderna. Estos productos, ofrecen soluciones eficaces y respetuosas con el agroecosistema, demostrando que la vida microscópica del suelo es el mayor aliado de la fertilidad y la sanidad vegetal.
El papel fundamental de los microorganismos en el ecosistema agrícola.
En agricultura, cuando hablamos de microorganismos, nos referimos a un extenso y complejo universo de bacterias, hongos, levaduras y otros organismos que, aunque invisibles a simple vista, desempeñan funciones vitales.
Su principal campo de acción es el suelo y, más concretamente, la rizosfera, esa delgada capa de tierra que rodea a las raíces y que constituye un hervidero de actividad biológica.
En este contexto, un suelo fértil no es un sustrato inerte, sino un ecosistema vivo donde millones de microorganismos interactúan con la planta. Ellos son los responsables de transformar la materia orgánica, reciclar nutrientes y ponerlos a disposición de los cultivos.
Por supuesto, cuando nos referimos a suelo y sustrato, nos referimos al campo o formulados con materia orgánica entre sus componentes, sacando de la ecuación los sustratos inertes utilizados en hidroponía, como son la perlita o la lana de roca para cultivo sin suelo, por ejemplo.
Entender y potenciar esta actividad microbiana es clave para optimizar la nutrición de las plantas y fortalecer sus defensas naturales. Entre los grupos más utilizados en la agricultura destacan las bacterias y los hongos, gracias a su enorme diversidad metabólica y a su capacidad para establecer relaciones beneficiosas con los cultivos.

¿Cómo benefician los microorganismos a los cultivos?
Los efectos de la aplicación de microorganismos en la agricultura son múltiples y complementarios. Actúan principalmente a través de dos vías: la mejora de la nutrición vegetal (biofertilización) y el control de patógenos (biocontrol).
En el ámbito de la nutrición, ciertos microorganismos tienen la capacidad de poner a disposición de la planta nutrientes que, de otra forma, serían inaccesibles. Un ejemplo clásico es la fijación biológica de nitrógeno, donde bacterias de géneros como Rhizobium (en simbiosis con leguminosas) o Azotobacter y Azospirillum (de vida libre) capturan el nitrógeno atmosférico (N2) y lo convierten en amonio (NH4+), una forma asimilable por la planta.
Otros son especialistas en la solubilización de fósforo y potasio. Bacterias (Pseudomonas, Bacillus) y hongos secretan ácidos orgánicos y enzimas, como las fosfatasas, que liberan estos macronutrientes bloqueados en la fracción mineral del suelo. Además, muchos producen sideróforos, unas moléculas que quelatan el hierro del suelo y facilitan su absorción por las raíces, un proceso crucial en suelos calizos con pH elevado.
Paralelamente, actúan como potentes bioestimulantes agrícolas. Producen fitohormonas como auxinas, giberelinas o citoquininas, que promueven el desarrollo radicular y el crecimiento general de la planta, mejorando su capacidad para hacer frente a situaciones de estrés abiótico como la sequía o la salinidad.
El control biológico de plagas y enfermedades por microorganismos.
En el campo de la sanidad vegetal, los microorganismos son una herramienta de gran valor para el control de patógenos. Su acción se basa en varios mecanismos que, a menudo, actúan de forma sinérgica. Ejemplos de estos son bacterias (Pseudomonas, Bacillus, Lactobacillus, Azotobacter, Azospirillum, Rhizobium …), levaduras (Saccharomyces, Candida …) y hongos (Glomus, Trichoderma …).
Uno de los más importantes es la competencia por el espacio y los nutrientes. Al colonizar la rizosfera, los microorganismos beneficiosos ocupan el nicho ecológico e impiden que los hongos patógenos del suelo (Fusarium, Pythium, Rhizoctonia, etc.) puedan instalarse y prosperar.
Otro mecanismo es la antibiosis, que consiste en la producción de metabolitos (antibióticos, enzimas líticas) que inhiben el crecimiento del patógeno o directamente lo destruyen.
Ciertos hongos, como los del género Trichoderma, son además micoparásitos, es decir, son capaces de atacar, enrollarse y alimentarse de las hifas de otros hongos fitopatógenos.
Por último, algunos microorganismos pueden activar las defensas propias de la planta, un fenómeno conocido como Resistencia Sistémica Inducida (ISR), que la prepara para responder de forma más rápida y eficaz ante el ataque de un patógeno.
La aplicación de microorganismos en la agricultura.
La biotecnología ha permitido aislar, seleccionar y producir a gran escala cepas específicas de microorganismos para abordar problemas concretos en los cultivos. Estos formulados se comercializan como marcas y como soluciones biológicas para acciones definidas.
Microorganismos para el control de insectos.
Los productos a base de Bacillus thuringiensis (Bt) son un referente. Cada subespecie produce toxinas específicas para un grupo de insectos: la subespecie kurstaki es eficaz contra larvas de lepidópteros (orugas), mientras que la israelensis se usa para el control de dípteros (mosquitos y moscas).
Hongos entomopatógenos como Beauveria bassiana y Metarhizium anisopliae también se emplean para controlar plagas como la mosca blanca, el pulgón o el picudo rojo.
Microorganismos para el control de enfermedades fúngicas.
Las distintas especies y cepas del hongo Trichoderma (T. harzianum, T. atroviride) son ampliamente utilizadas para la prevención de enfermedades de suelo.
Aplicadas en el riego o en el sustrato, protegen el sistema radicular de hongos patógenos.
Microorganismos para el control de nematodos.
El hongo Purpureocillium lilacinum (anteriormente Paecilomyces lilacinus) es un parásito de los huevos de nematodos, reduciendo su población en el suelo.
También se emplean bacterias como Bacillus firmus, que crean una barrera protectora alrededor de las raíces que impide la penetración de estos parásitos.
Microorganismos como biofertilizantes y mejoradores de suelo.
Los inoculantes con Rhizobium son esenciales para maximizar la fijación de nitrógeno en cultivos de leguminosas. Para otros cultivos, se utilizan mezclas de Rizobacterias Promotoras del Crecimiento Vegetal (PGPR), que incluyen géneros como Azospirillum, Bacillus o Pseudomonas.
Las micorrizas, una simbiosis entre hongos del género Glomus y las raíces de las plantas, son fundamentales para mejorar la captación de fósforo y agua, siendo especialmente valiosas en cultivos leñosos como frutales y viñedo.
La aplicación de los microorganismos.
El éxito de un tratamiento con microorganismos depende en gran medida de una correcta aplicación. Estos productos se presentan en diversas formulaciones (líquidos, polvos mojables, granulados) adaptadas a distintos sistemas, ya sea tratamiento de semillas, aplicación en el surco de siembra o inyección a través del riego por goteo.
Al tratarse de organismos vivos, es muy importante tener en cuenta su compatibilidad. El agricultor o técnico debe consultar la ficha técnica del producto para conocer su sensibilidad a temperaturas extremas, al cloro del agua de riego o a la mezcla con ciertos fungicidas o bactericidas que podrían mermar su viabilidad.
Marco regulatorio de los microorganismos.
Desde el punto de vista regulatorio, los microorganismos están amparados por normativas específicas. Pueden registrarse como productos fitosanitarios de origen microbiano o, en el marco del Reglamento (UE) 2019/1009, dependiendo de su función principal.
En cualquier caso, su uso, siempre que no se trate de organismos modificados genéticamente, está plenamente autorizado y fomentado en agricultura ecológica, ya que responde a su principio básico de «fertilizar el suelo para bioestimular o nutrir a la planta«.
La investigación en este campo no cesa. Cada día, centros de investigación y empresas dedican más recursos al aislamiento de nuevas cepas, al estudio de consorcios microbianos y al conocimiento del microbioma de los cultivos.
Esta evolución garantiza que los microorganismos seguirán ganando protagonismo como una herramienta tecnológica de primer orden para una agricultura más productiva, rentable y sostenible.







